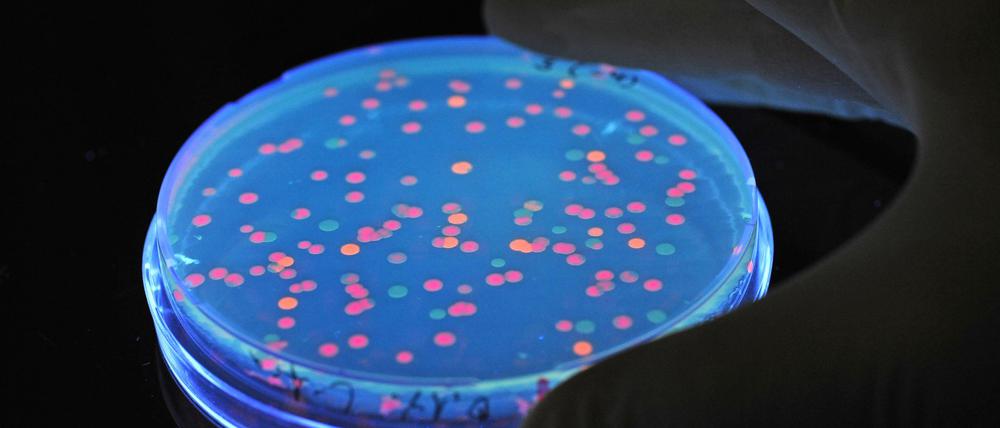
Verschiedene Bevölkerungsgruppen haben ein unterschiedlich hohes Vertrauen in Forscher. (Archivbild)

© picture alliance / dpa
Meinung und Wissenschaft: 68-Länder Befragung zeigt Vertrauen in Forscher
Am Tag der Amtseinführung von Donald Trump als US-Präsident präsentiert ein internationales Team Daten zum Vertrauen in Forscher. Weltweit sieht es ganz gut aus, es gibt aber Kritik an der Studie.
Stand:
Das Vertrauen in Forscher ist weltweit gesehen auf „moderat hohem“ Niveau. Zu diesem Ergebnis kommt eine Befragung von knapp 72.000 Menschen aus 68 Ländern. Die Studie widerlege die Erzählung einer weitreichenden Vertrauenskrise in Wissenschaftler, schreibt das Team von 241 Forschern im Journal „Nature Human Behaviour“. Es gibt jedoch einige Kritikpunkte am Messverfahren der Arbeit, insbesondere an der Vergleichbarkeit der Länder.
Die Mehrheit der Menschen wünsche sich, dass sich Forscher in Politik und Gesellschaft einbringen, berichtet das Team unter Leitung von Viktoria Cologna (Eidgenössische Technische Hochschule ETH Zürich) und Niels Mede (Universität Zürich).
Frauen und religiöse Menschen haben höheres Vertrauen in Forscher
Einige demografische Gruppen vertrauen Forschern laut Studie besonders. Dazu zählten Frauen, ältere Menschen und Menschen mit hohem Einkommen. Auch religiöse Menschen, gebildete, liberale sowie Menschen mit linker politischer Orientierung vertrauten Wissenschaftlern eher. Bewohner städtischer Gebiete hätten ein höheres Vertrauen zu Forschern als solche auf dem Land.
„Tatsächlich fanden wir heraus, dass Religiosität insgesamt positiv mit Vertrauen in Wissenschaftler assoziiert ist“, schreibt das Team. Eine Studie von 2020 habe gezeigt, dass die meisten muslimischen Teilnehmer keinen Konflikt zwischen Wissenschaft und Religion wahrnehmen, da der Koran viele Prinzipien der Wissenschaft enthalte. Einige Christen empfanden in der früheren Studie jedoch, dass Wissenschaft im Widerspruch zu ihrer Religion stehe – es gebe dabei aber deutliche Unterschiede zwischen den Ländern.
Ein relativ geringes Forscher-Vertrauen hatten dagegen in vielen Ländern Menschen mit rechtsgerichteten und konservativen politischen Ansichten. „Angesichts des weltweit zunehmenden Einflusses autoritär-populistischer Parteien und Strömungen – wie der AFD in Deutschland oder der FPÖ in Österreich – sehe ich hier eine nicht zu unterschätzende Herausforderung für die Wissenschaft und die Wissenschaftskommunikation in den kommenden Jahren“, sagte der Philosoph Mathias Frisch von der Universität Hannover, der nicht an der Studie beteiligt war.
Befragte halten Wissenschaftler für vertrauenswürdig
In allen analysierten Ländern hält eine Mehrheit der Bevölkerung Wissenschaftler für vertrauenswürdig. Zur Ermittlung des Wertes nutzten die Forscher Antworten zu den Bereichen Kompetenz, zum Wohlwollen der Forscher, zur Integrität und zu ihrer Offenheit. Die Befragten konnten wählen zwischen 1 (sehr niedrig), 2 (eher niedrig), 3 (weder hoch noch niedrig) 4 (eher hoch) und 5 (sehr hoch). Insgesamt erreichte das Vertrauen in Wissenschaftler laut Studie einen Mittelwert von 3,62.
Deutschland liegt dabei mit 3,49 auf Platz 44 von 68. Dort wurden mehr als 8.000 Menschen befragt. Die Vertrauensskala reicht von Albanien (3,05) und Kasachstan (3,13) bis hoch zu Ägypten (4,30) und Indien (4,26). Insgesamt zeigten Russland sowie mehrere ehemalige Sowjetrepubliken und Satellitenstaaten ein vergleichsweise niedriges Vertrauen in Wissenschaftler.
Studie hat Einschränkungen
Der wichtigste Beitrag der Studie sei darin zu sehen, dass sie den Mythos von der gefährlich geringen Vertrauenswürdigkeit von Wissenschaftlern ausräumt, kommentiert Frank Marcinkowski von der Universität Düsseldorf. „Kein gemessener Ländermittelwert liegt unterhalb des Mittelpunkts der verwendeten 5er-Skala.“
Er schränkte jedoch ein: „Angesichts offensichtlicher Differenzen in den sozialen, kulturellen, politischen, ökonomischen und anderen Randbedingungen von Wissenschaft in den einzelnen Ländern, scheint es mir kaum möglich, die Länderwerte direkt aufeinander zu beziehen.“ Zudem gebe es „keine theoretisch begründete Vorstellung von dem richtigen Maß an Vertrauen, das die Wissenschaft genießen sollte“.
Insgesamt stimmen 75 Prozent der Befragten zu, dass wissenschaftliche Forschungsmethoden der beste Weg sind um herauszufinden, ob etwas wahr oder falsch ist. Weltweit wünschen 83 Prozent, dass Forschende mit der breiten Öffentlichkeit kommunizieren.
Die Studie habe mehrere Einschränkungen, räumen auch die Forscher selbst ein. So wurde die Umfrage in einigen Ländern auf Englisch oder Französisch geführt, auch wenn diese dort nicht die am häufigsten gesprochenen Sprachen sind. Zudem erfolgte die Umfrage online. Beides könnte zur Überrepräsentation gebildeter Menschen geführt haben. Die Begriffe „Wissenschaft“ und „Wissenschaftler“ könnten zudem in verschiedenen Ländern etwas unterschiedlich interpretiert werden.
Minderheit mit möglichem Einfluss
„Es gibt zwar keinen weit verbreiteten Mangel an Vertrauen an Wissenschaftlern“, schließt das Team, „wir können aber die Sorge nicht ausschließen, dass ein Mangel an Vertrauen in Wissenschaftler selbst bei einer kleinen Minderheit die Berücksichtigung wissenschaftlicher Erkenntnisse bei der politischen Entscheidungsfindung beeinflussen kann.“
© dpa-infocom, dpa:250120-930-349740/1
Das ist eine Nachricht direkt aus dem dpa-Newskanal.
- showPaywall:
- false
- isSubscriber:
- false
- isPaid: